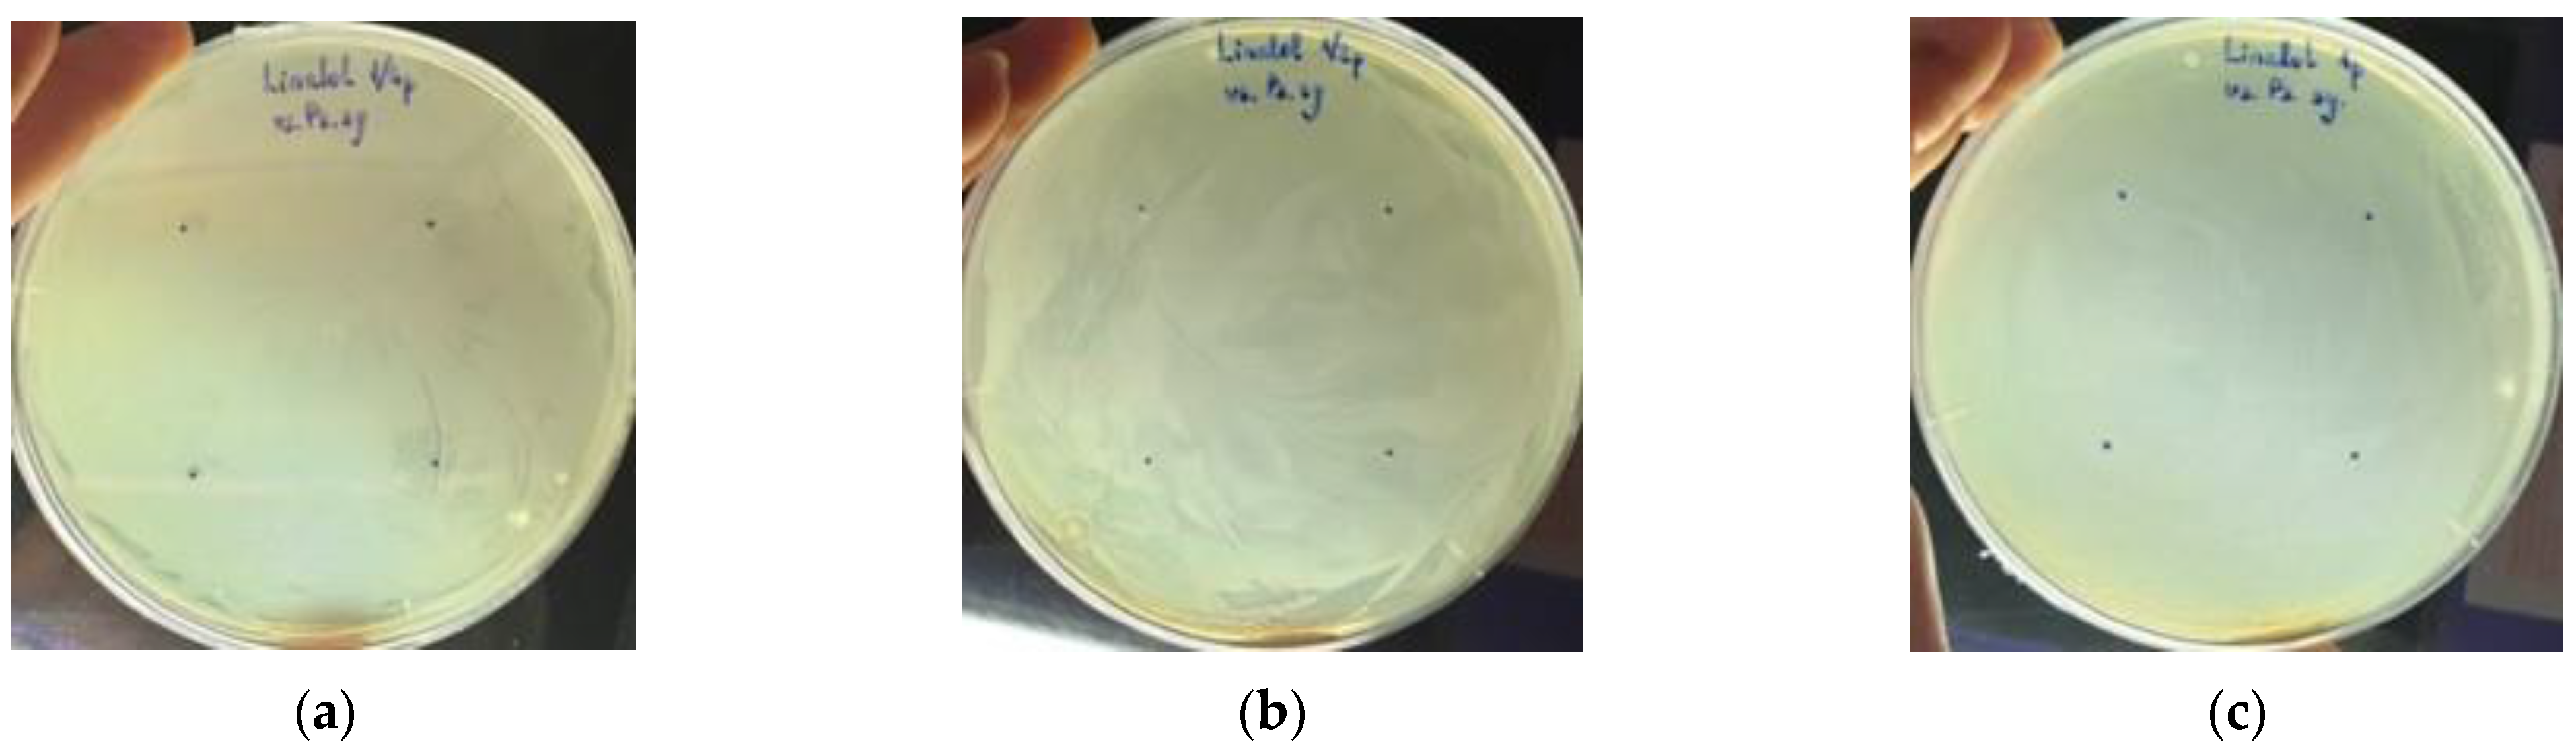
Diversity 14 01048 g003 Diversity 14 01048 g003
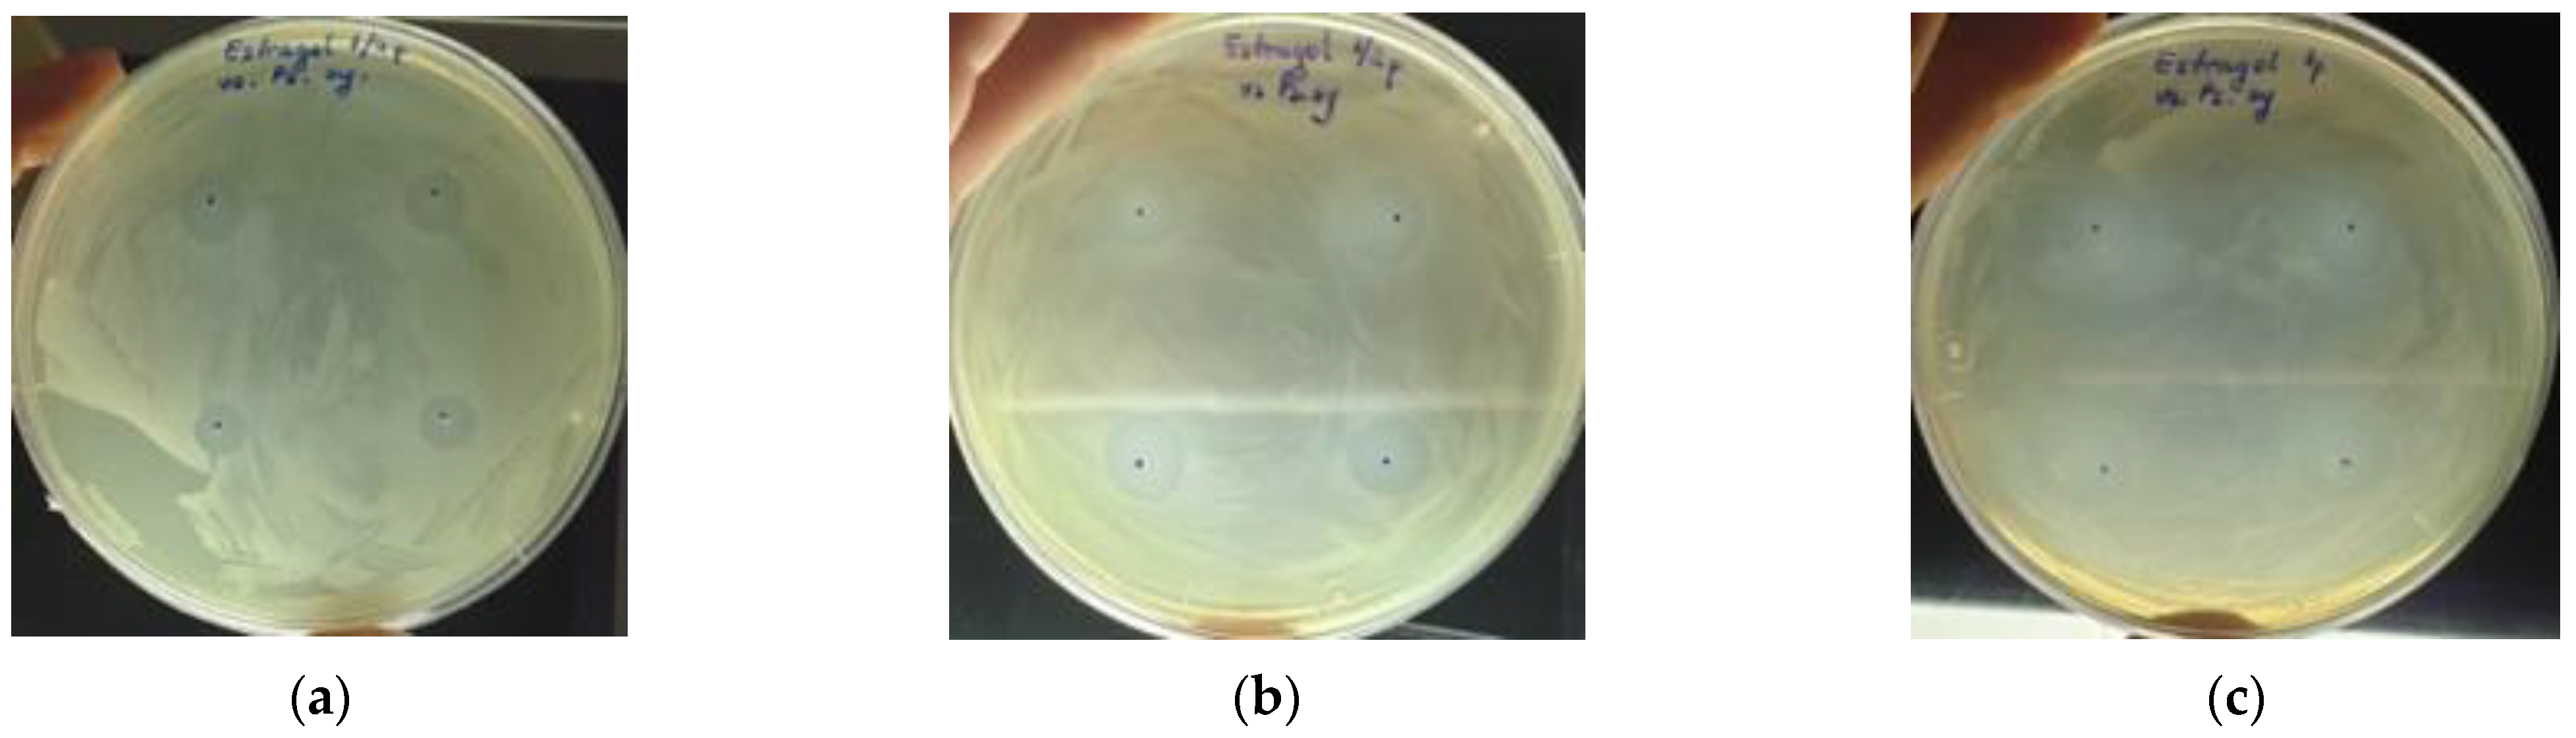
Diversity 14 01048 g004 Diversity 14 01048 g004
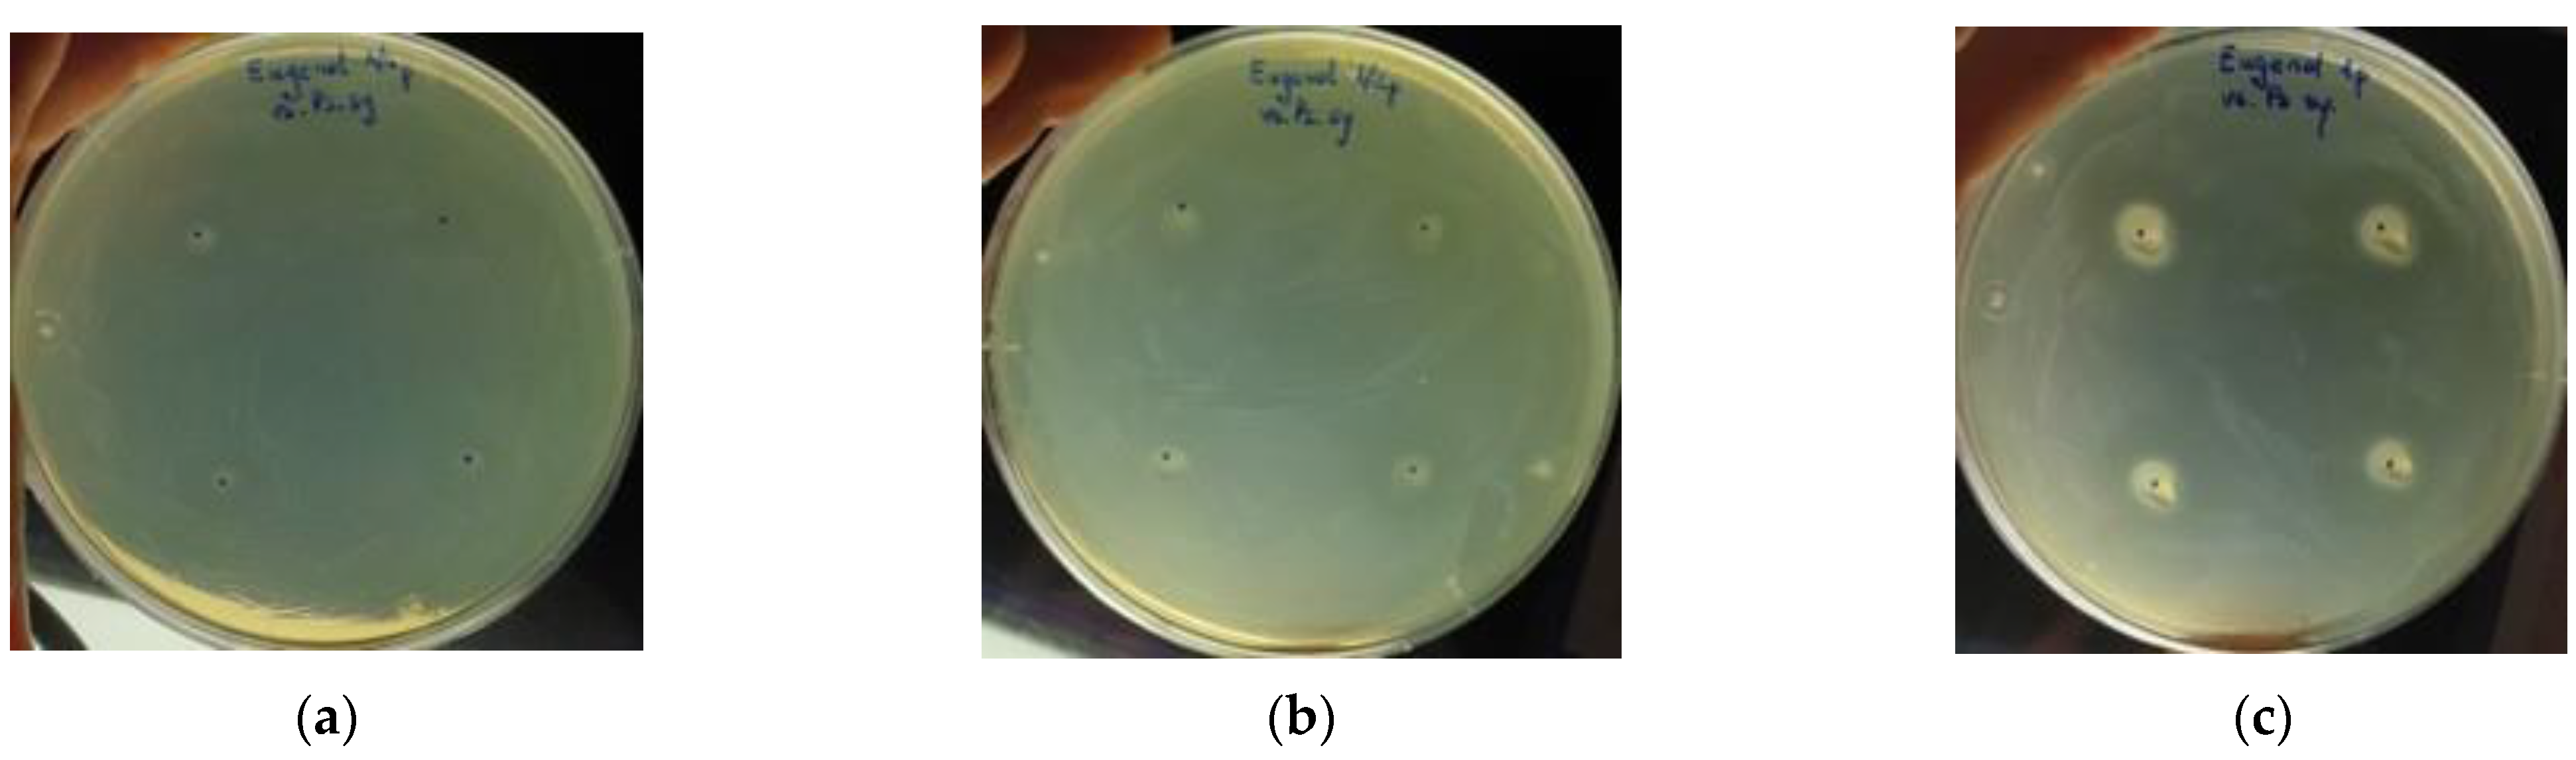
Diversity 14 01048 g005 Diversity 14 01048 g005
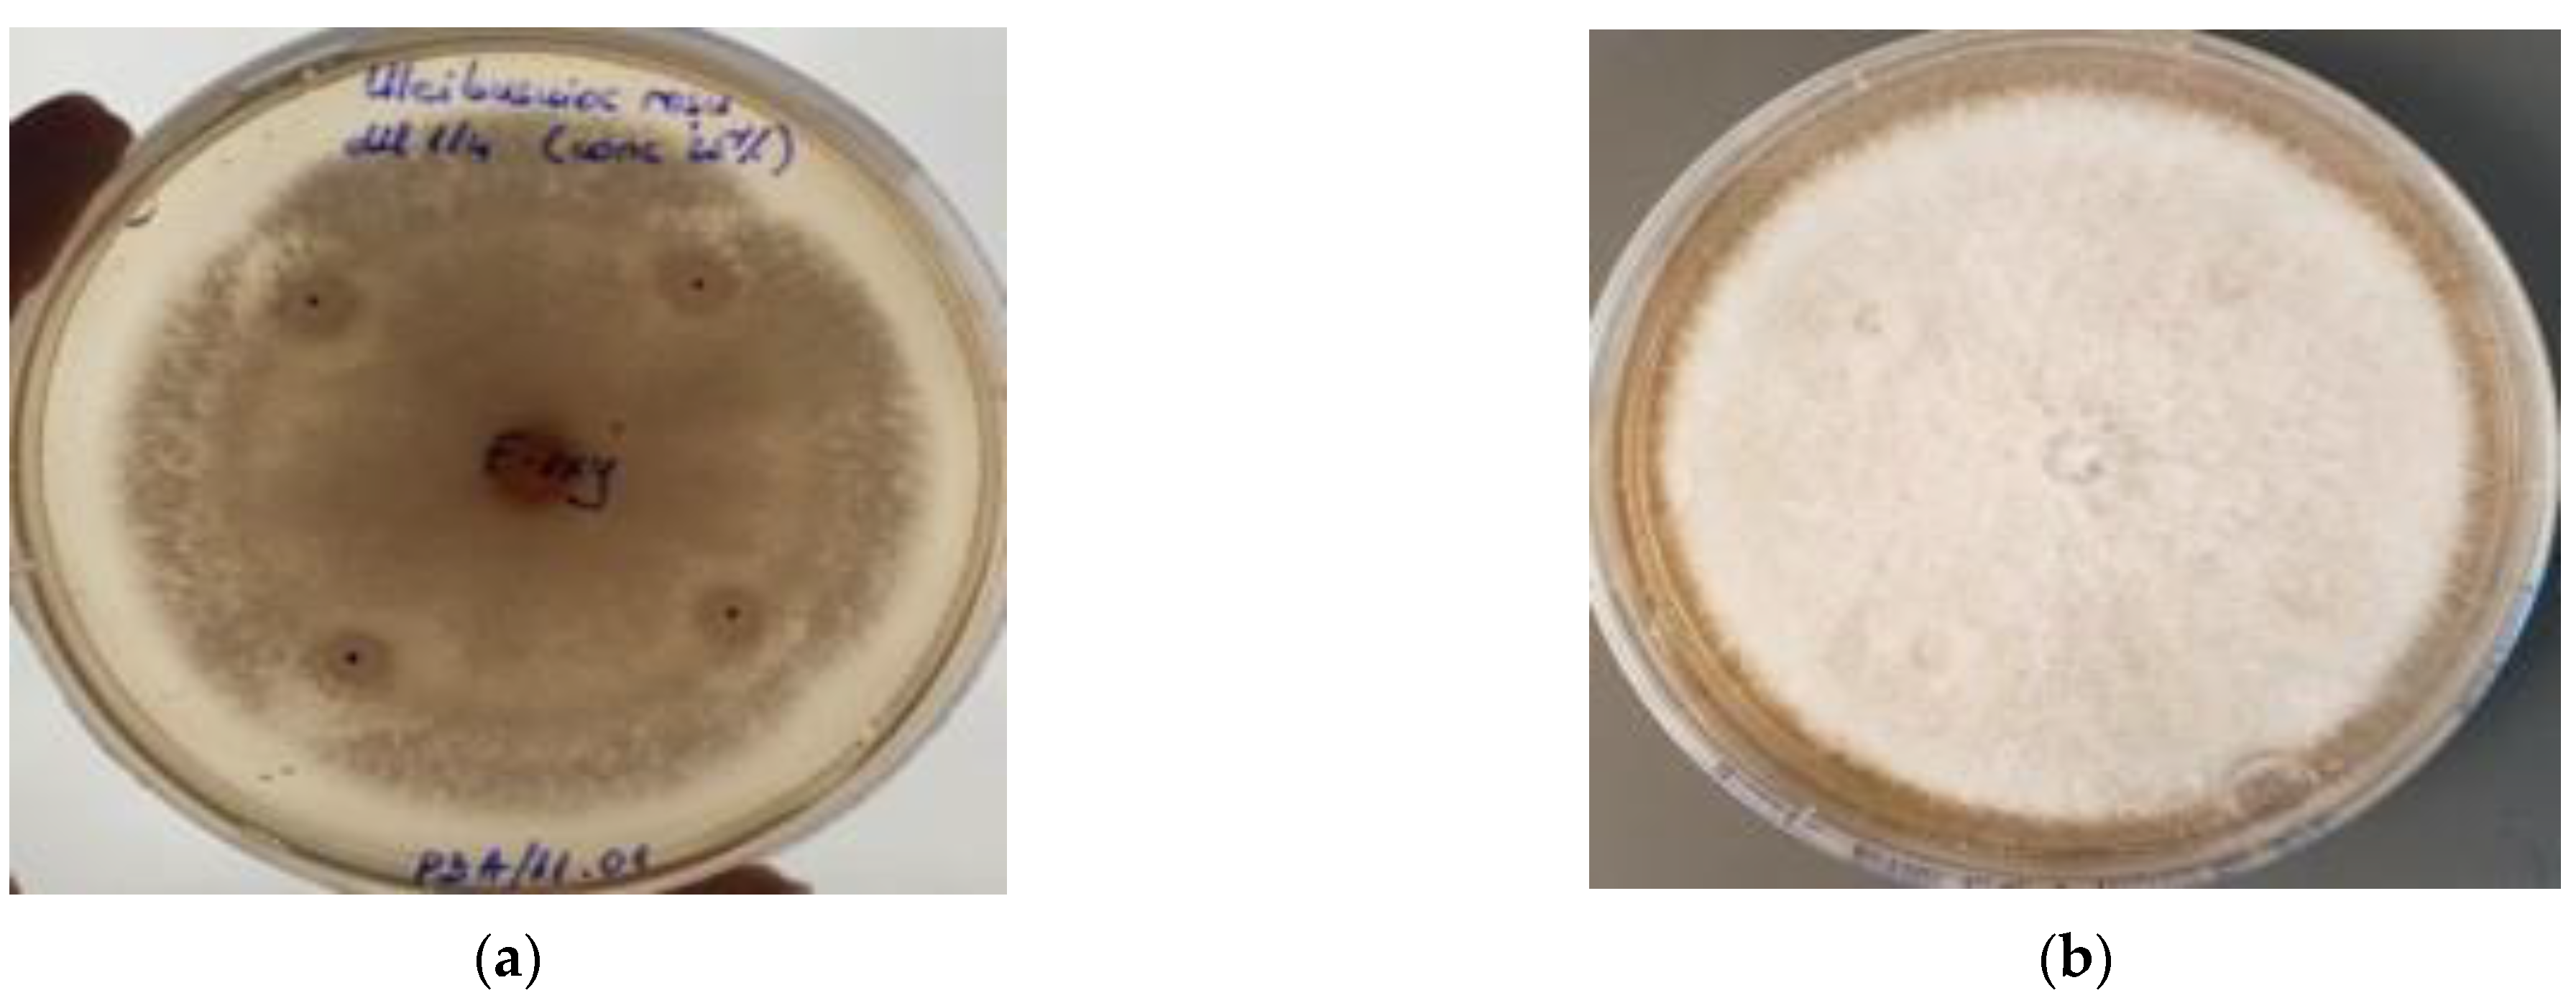
Diversity 14 01048 g009 Diversity 14 01048 g009
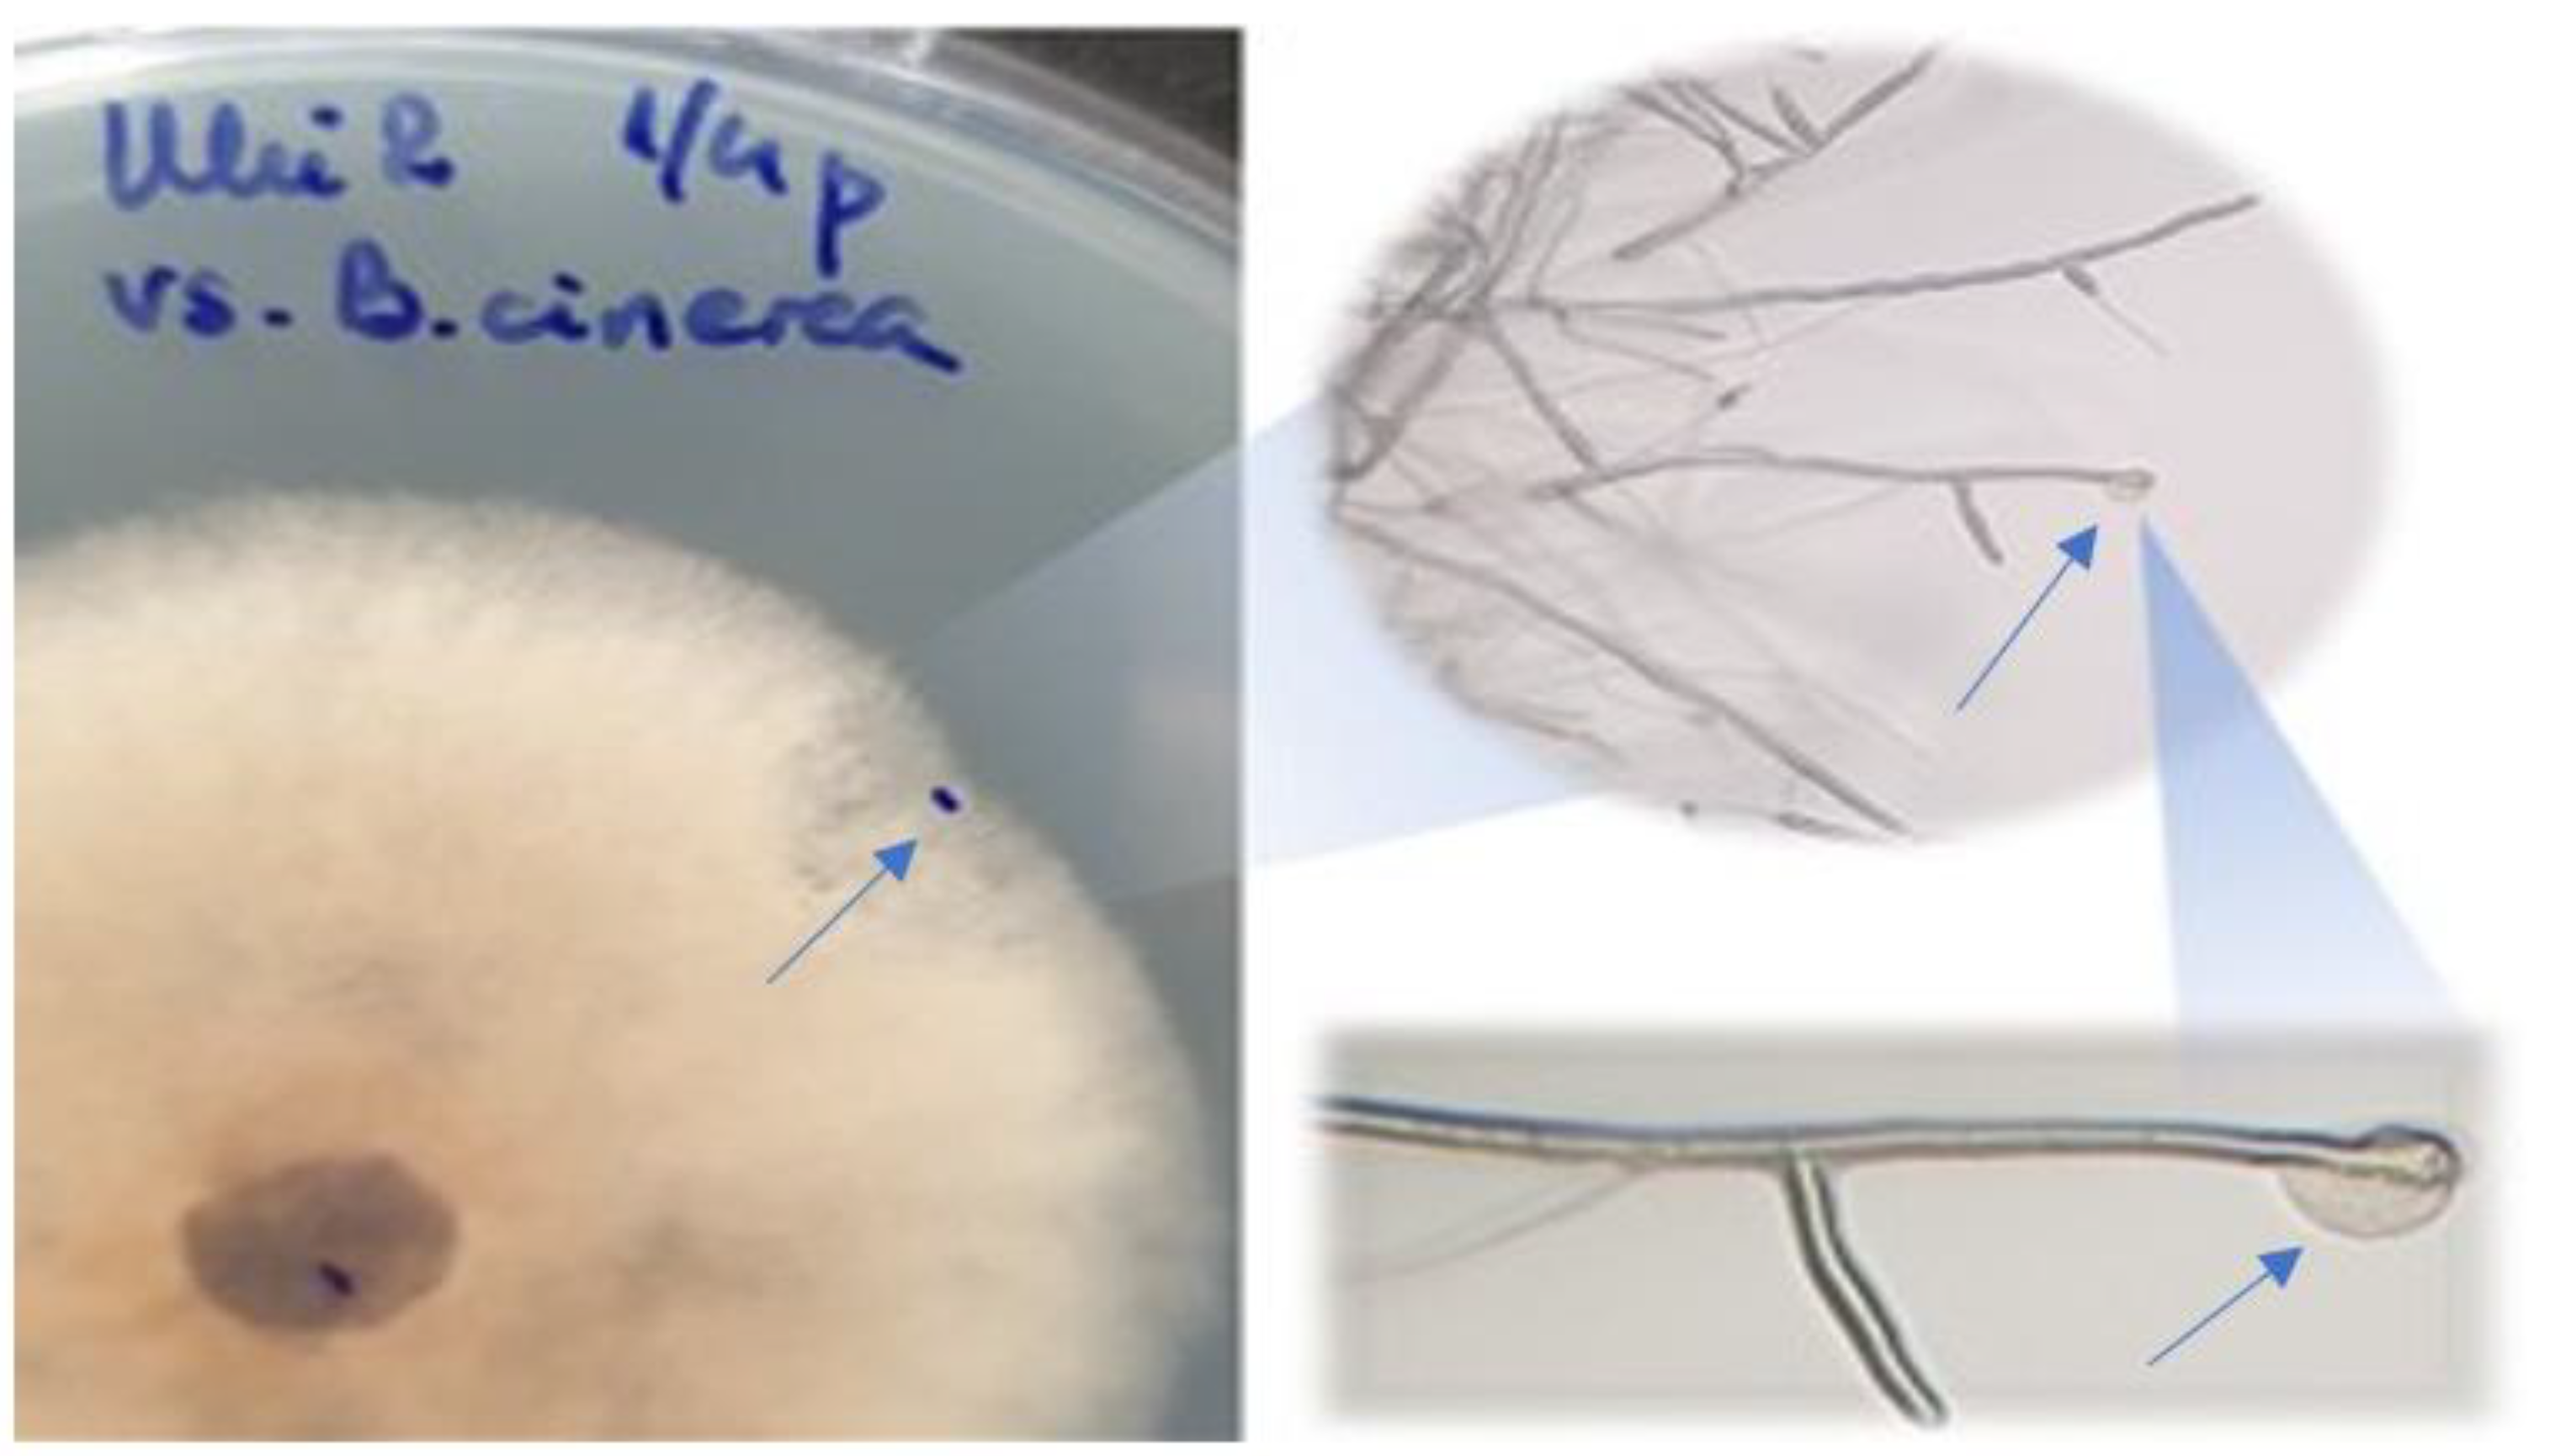
Diversity 14 01048 g011 Diversity 14 01048 g011

Chemical Composition, Antioxidant and Antimicrobial Effects of Essential Oils Extracted from Two New Ocimum basilicum L. Varieties
Abstract
1. Introduction
- the European chemotype with the main compounds linalool of very good quality in a proportion of at least 50%, eugenol 4–5%, and methyl chavicol (estragole) 2–3%;
- tropical chemotype rich in methyl cinnamate 50–70%, linalool 8–30%, and high content of camphor;
- reunion chemotype, characterized by high concentrations of methyl chavicol (estragole);
- eugenol-rich chemotype, characterized by high concentrations of eugenol (>5%).
2. Materials and Methods
2.1. Plant Materials
2.2. EOS and FWS Extraction
2.3. EOS and FWS Analysis
2.4. Analysis of EOS and FWS Antioxidant Activity
- A.
- The scavenger activity of the DPPH radical (2,2-diphenyl-1-picrylhydrazyl) is based on the ability of antioxidants to reduce the DPPH radical. The percentage of DPPH remaining in the solution is calculated according to Equation (2):where Acontrol sample is the absorbance of the control sample and Asample is the absorbance of the sample.
- B.
- The scavenger activity of the ABTS radical (2,2′-azinobis(3-ethylbenzothiazoline-6-sulfonic acid))—the method is known as Trolox equivalent antioxidant capacity (TEAC) since the expression of the antioxidant capacity of the extracts can be associated with Trolox equivalents. The antioxidant capacity was expressed in mM Trolox using 3 calibration curves of the Trolox standard.
- C.
- Ferric ion Reducing Antioxidant Power (FRAP)—is based on the ability of antioxidants to reduce the yellow-colored tripyridyltriazine—Fe3+ (Fe(III)-TPTZ) complex to the blue-colored tripyridyltriazine—Fe2+ (Fe(II)-TPTZ) complex, by the action of electron release by antioxidants. The samples were worked in triplicate, and the FRAP values of each sample were expressed in mM Trolox g−1 for EOs and L−1 h for FWs, respectively.
2.5. Microbial Strains and Growth Conditions
2.6. Evaluation of Essential Oils Emulsions
2.7. Antibacterial Assay
2.8. Antifungal Assay
2.9. Statistical Analysis
3. Results
3.1. EOs and FWs Chemical Composition Evaluation with GC-MS
3.2. Antioxidant Activity of the EOs and FWs
3.3. Antibacterial Activity of the EOs
3.4. Antifungal Activity of the EOs
4. Discussion
4.1. Chemical Composition of the Essential Oils (EOs) and Floral Waters (FWs), Obtained from the Two New Varieties of Basil
4.2. Antioxidant Potential Assessment for Basil EOs and FWs
4.3. Antibacterial Potential Assessment of Basil EOs
4.4. Antifungal Potential Assessment of Basil EOs
4.5. Statistical Analysis of Antifungal Activity Results
5. Conclusions
Author Contributions
Funding
Institutional Review Board Statement
Data Availability Statement
Acknowledgments
Conflicts of Interest
Abbreviations
References
- Dresselhaus, T.; Hückelhoven, R. Biotic and abiotic stress responses in crop plants. Agronomy 2018, 8, 267. [Google Scholar] [CrossRef]
- Salvi, P.; Agarrwal, R.; Kajal; Gandass, N.; Manna, M.; Kaur, H.; Deshmukh, R. Sugar transporters and their molecular tradeoffs during abiotic stress responses in plants. Physiol. Plant 2022, 174, e13652. [Google Scholar] [CrossRef] [PubMed]
- Mircea, C.; Nenciu, F.; Vlǎduț, V.; Voicu, G.; Cujbescu, D.; Gageanu, I.; Voicea, I. Increasing the performance of cylindrical separators for cereal cleaning, by using an inner helical coil. INMATEH Agric. Eng. 2020, 62, 249–258. [Google Scholar] [CrossRef]
- Nenciu, F.; Voicea, I.; Cocarta, D.M.; Vladut, V.N.; Matache, M.G.; Arsenoaia, V.-N. “Zero-Waste” Food Production System Supporting the Synergic Interaction between Aquaculture and Horticulture. Sustainability 2022, 14, 13396. [Google Scholar] [CrossRef]
- Al-Ahmadi, M.S. Pesticides, anthropogenic activities, and the health of our environment safety. In Pesticides-Use and Misuse and Their Impact in the Environment; Larramendy, M., Soloneski, S., Eds.; IntechOpen: London, UK, 2019; pp. 1–23. [Google Scholar]
- Duran-Lara, E.F.; Valderrama, A.; Marican, A. Natural organic compounds for application in organic farming. Agriculture 2020, 10, 41. [Google Scholar] [CrossRef]
- Nenciu, F.; Oprescu, M.R.; Biris, S.-S. Improve the Constructive Design of a Furrow Diking Rotor Aimed at Increasing Water Consumption Efficiency in Sunflower Farming Systems. Agriculture 2022, 12, 846. [Google Scholar] [CrossRef]
- Nenciu, F.; Paraschiv, M.; Kuncser, R.; Stan, C.; Cocarta, D.; Vladut, V.N. High-Grade Chemicals and Biofuels Produced from Marginal Lands Using an Integrated Approach of Alcoholic Fermentation and Pyrolysis of Sweet Sorghum Biomass Residues. Sustainability 2022, 14, 402. [Google Scholar] [CrossRef]
- Simon, J.E.; Morales, M.R.; Phippen, W.P.; Vieira, R.F.; Hao, Z. Basil: A Source of Aroma Compounds and a Popular Culinary and Ornamental Herb; Janick, J., Ed.; ASHS Press: Alexandria, Egypt, 1999. [Google Scholar]
- Lee, S.J.; Umano, K.; Shibamoto, T.; Lee, K.G. Identification of volatile components in basil (Ocimum basilicum L.) and thyme leaves (Thymus vulgaris L.) and their antioxidant properties. Food Chem. 2005, 91, 131–137. [Google Scholar] [CrossRef]
- Telci, I.; Bayram, E.; Yilmaz, G.; Avci, B. Variability in essential oil composition of Turkish basils (Ocimum basilicum L.). Biochem. System. Ecol. 2006, 34, 489–497. [Google Scholar] [CrossRef]
- Technavio. Available online: https://www.technavio.com/ (accessed on 27 August 2022).
- Sestili, P.; Ismail, T.; Calcabrini, C.; Guescini, M.; Catanzaro, E.; Turrini, E.; Layla, A.; Akhtar, S.; Fimognari, C. The potential effects of Ocimum basilicum on health: A review of pharmacological and toxicological studies. Expert Opin. Drug Metab. Toxicol. 2018, 14, 679–692. [Google Scholar] [CrossRef]
- Antonescu, A.-I.; Miere, F.; Fritea, L.; Ganea, M.; Zdrinca, M.; Dobjanschi, L.; Antonescu, A.; Vicas, S.I.; Bodog, F.; Sindhu, R.K.; et al. Perspectives on the combined effects of Ocimum basilicum and Trifolium pratense extracts in terms of phytochemical profile and pharmacological effects. Plants 2021, 10, 1390. [Google Scholar] [CrossRef]
- Srivastava, A.; Gupta, A.K.; Sarkar, S.; Lal, R.K.; Yadav, A.; Gupta, P.; Chanotiya, C.S. Genetic and chemotypic variability in basil (Ocimum basilicum L.) germplasm towards future exploitation. Ind. Crops Prod. 2018, 112, 815–820. [Google Scholar] [CrossRef]
- De Araújo Couto, H.G.S.; Blank, A.F.; de Oliveira e Silva, A.M.; de Lima Nogueira, P.C.; de Fátima Arrigoni-Blank, M.; de Castro Nizio, D.A.; de Oliveira Pinto, J.A. Essential oils of Basil chemotypes: Major compounds, binary mixtures and antioxidant activity. Food Chem. 2019, 293, 446–454. [Google Scholar] [CrossRef]
- Bayala, B.; Bassole, I.H.N.; Gnoula, C.; Nebie, R.; Yonli, A.; Morel, L.; Figueredo, G.; Nikiema, J.B.; Lobaccaro, J.M.A.; Simpore, J. Chemical composition, antioxidant, anti-inflammatory and anti-proliferative activities of essential oils of plants from Burkina Faso. PLoS ONE 2014, 9, e92122. [Google Scholar] [CrossRef]
- Hanif, M.A.; Al-Maskari, M.Y.; Al-Maskari, A.; Al-Shukaili, A.; Al-Maskari, A.Y.; Al-Sabahi, J.N. Essential oil composition, antimicrobial and antioxidant activities of unexplored Omani basil. J. Med. Plants Res. 2011, 5, 751–757. [Google Scholar]
- Bozin, B.; Mimica, D.; Simin, N.; Anackov, G. Characterization of the volatile composition of essential oils of some Lamiaceae spices and the antimicrobial and antioxidant activities of the entire oils. J. Agric. Food Chem. 2006, 54, 1822–1828. [Google Scholar] [CrossRef]
- Abbas, A.; Anwar, F.; Ahmad, N. Variation in Physicochemical Composition and Biological Attributes of Common Basil Essential Oils Produced by Hydro-distillation and Super Critical Fluid Extraction. J. Essent. Oil Bear. Plants 2017, 20, 95–109. [Google Scholar] [CrossRef]
- Pieroni, A.; Quave, C.L.; Giusti, M.E.; Papp, N. “We Are Italians!”: The Hybrid Ethnobotany of a Venetian Diaspora in Eastern Romania. Hum. Ecol. 2012, 40, 435–451. [Google Scholar] [CrossRef]
- Dafni, A.; Petanidou, T.; Vallianatou, I.; Kozhuharova, E.; Blanche, C.; Pacini, E.; Peiman, M.; Stevanovic, Z.D.; Franchi, G.G.; Benitez, G. Myrtle, Basil, Rosemary, and Three-Lobed Sage as Ritual Plants in the Monotheistic Religions: An Historical–Ethnobotanical Comparison. Econ. Bot. 2020, 74, 330–355. [Google Scholar] [CrossRef]
- Dajić Stevanović, Z.; Petrović, M.; Aćić, S. Ethnobotanical Knowledge and Traditional Use of Plants in Serbia in Relation to Sustainable Rural Development. In Ethnobotany and Biocultural Diversities in the Balkans; Pieroni, A., Quave, C., Eds.; Springer: New York, NY, USA, 2014. [Google Scholar] [CrossRef]
- Adams, R.P. Identification of Essential Oil Components by Gas Chromatography/Mass Spectrometry, 4th ed.; Allured Publishing Corporation: Carol Stream, IL, USA, 2007. [Google Scholar]
- Boulos, L. Medicinal Plants of North Africa; Reference Publications, Inc.: Algonac, MI, USA, 1983. [Google Scholar]
- Alexiou, M. The Ritual Lament in Greek Tradition, 2nd ed.; Rowman & Littlefield Publishers: Lanham, MD, USA, 2002. [Google Scholar]
- Wright, P.J.; Hale, C.N. A field and storage rot of onion caused by Pseudomonas marginalis. N. Zeal. J. Crop Hortic. Sci. 1992, 20, 435–438. [Google Scholar] [CrossRef]
- Kůdela, V.; Krejzar, V.; Pánková, I. Pseudomonas corrugata and Pseudomonas marginalis associated with the collapse of tomato plants in Rockwool slab hydroponic culture. Plant Protect. Sci. 2010, 46, 1–11. [Google Scholar] [CrossRef]
- Krejzar, V.; Mertelík, J.; Pánková, I. Pseudomonas marginalis Associated with Soft Rot of Zantedeschia spp. Plant Prot. Sci. 2008, 44, 85–90. [Google Scholar] [CrossRef]
- Jinhua, L.; Zhaoxiang, C.; Hetong, Y.; Guoquan, L.; Di, W. First report of Pseudomonas marginalis pv. marginalis as a cause of soft rot of potato in China. Australas. Plant Dis. Notes 2007, 2, 71–73. [Google Scholar]
- Xin, X.F.; Kvitko, B.; He, S.Y. Pseudomonas syringae: What it takes to be a pathogen. Nature reviews. Microbiology 2018, 16, 316–328. [Google Scholar] [PubMed]
- Boyraz, N.; Bastas, K.K.; Maden, S.; Yasar, A. Bacterial leaf and peduncle soft rot caused by Pectobacterium carotovorum on tulips in Konya, Turkey. Phytoparas 2006, 34, 272–280. [Google Scholar] [CrossRef]
- Raymond, G.A.T.; Roland, T.V.F. Diseases of Temperate Horticultural Plants; Edit. CAB International: New York, NY, USA, 2014; p. 488. [Google Scholar]
- Enciclopedia of Life. Available online: https://eol.org/ (accessed on 19 September 2022).
- Prabuseenivasan, S.; Jayakumar, M.; Ignacimuthu, S. In vitro antibacterial activity of some plant essential oils. BMC Comp. Altern. Med. 2006, 6, 39. [Google Scholar] [CrossRef]
- Lahlali, R.; Hijri, M. Screening, identification and evaluation of potential biocontrol fungal endophytes against Rhizoctonia solani AG3 on potato plants. FEMS Microbiol. Lett. 2010, 311, 52–159. [Google Scholar] [CrossRef]
- MathSoft Incorporation. Mathcad Reference Manual; MathSoft Incorporation: Cambridge, MA, USA, 2000. [Google Scholar]
- Santana-Rios, G.; Orner, G.A.; Amantana, A.; Provost, C.; Wu, S.Y.; Dashwood, R.H. Potent antimutagenic activity of white tea in comparison with green tea in the Salmonella assay. Mutat. Res. Genet. Toxicol. Environ. Mutagen. 2001, 495, 61–74. [Google Scholar] [CrossRef]
- Hoet, S.; Stevigny, C.; Herent, M.F.; Quentin-Leclercq, J. Antitrypanosomal compounds from the leaf essential oil of Strychnos spinosa. Planta Med. 2006, 72, 480–482. [Google Scholar] [CrossRef]
- Chen, Y.; Zhu, Z.; Guo, Q.; Zhang, L.; Zhang, X. Variation in concentrations of major bioactive compounds in Prunella vulgaris L. related to plant parts and phonological stages. Biol. Res. 2012, 45, 171–175. [Google Scholar] [CrossRef]
- Silva, M.G.; Matos, F.J.; Machado, M.I.; Craveiro, A.A. Essential oils of Ocimum basilicum L., Ocimum basilicum var. minimum L. and Ocimum basilicum var. purpurascens Benth. grown in north-eastern Brazil. Flavour Frag. J. 2003, 18, 13–14. [Google Scholar] [CrossRef]
- Abhay, K.P.; Pooja, S.; Nijendra, N.; Tripathi, I. Chemistry and bioactivities of essential oils of some Ocimum species: An overview. Asian Pac. J. Trop. Biomed. 2014, 4, 682–694. [Google Scholar]
- Mohhiuddin, M.; Chowdhury, M.J.; Alam, M.K.; Hossain, M.K. Chemical composition of essential oil of four flavouring plants used by the tribal people of Bandarban hill district in Bangladesh. Int. J. Med. Arom. Plants 2012, 2, 106–113. [Google Scholar]
- Sajjadi, S.E. Analysis of the essential oils of two cultivated basil (Ocimum basilicum L.) from Iran. DARU J. Pharm. Sci. 2006, 14, 128–130. [Google Scholar]
- Ololande, Z.S.; Fakankun, O.A.; Alao, F.O.; Udi, O.U. Ocimum basilicum var. purpureum floral essential oil: Phytochemicals, phenolic content, antioxidant, free radical scavenging and antimicrobial potentials. Glob. J. Sci. Front. Res. B Chem. 2014, 14, 30–37. [Google Scholar]
- Ahmed, H.A.; Hussein, K.; Alsyari, H.A.; Ibrahim, M.H.; Altanobi, L. Chemotaxonomy and spectral analysis (GC/MS and FT-IR) of essential oil composition of two Ocimum basilicum L. varieties and their morphological characterization. Jordan J. Chem. 2017, 12, 147–160. [Google Scholar]
- Ilić, A.S.; Antić, M.P.; Jelačić, S.C.; Šolević Knudsen, T.M. Chemical composition of the essential oils of three Ocimum basilicum L. cultivars from Serbia. Not. Bot. Horti Agrobot. 2019, 47, 347–351. [Google Scholar] [CrossRef]
- Benedec, D.; Oniga, I.; Oprean, P.; Tamas, M. Chemical composition of the essential oils of Ocimum basilicum L. cultivated in Romania. Farmacia 2009, 57, 625–629. [Google Scholar]
- Shatar, S.; Altantsetseg, S.H.; Sarnai, I.; Zoljargal, D.; Thang, T.D.; Nguyen, X.D. Chemical composition of the essential oil of Ocimum basilicum cultivated in Mongolian Desert-Gobi. Chem. Nat. Compd. 2007, 43, 726–727. [Google Scholar] [CrossRef]
- Beatović, D.; Krstić-Milošević, D.; Trifunović, S.; Šiljegović, J.; Glamočlija, J.; Ristić, M.; Jelačić, S. Chemical Composition, Antioxidant and Antimicrobial Activities of the Essential Oils of Twelve Ocimum basilicum L. Cultivars Grown in Serbia. Rec. Nat. Prod. 2015, 9, 62–75. [Google Scholar]
- Chenni, M.; El-Abed, D.; Rakotomanomana, N.; Fernandez, X.; Chemat, F. Comparative study of essential oils extracted from Egyptian basil leaves (Ocimum basilicum L.) using Hydro-Distillation and Solvent-Free Microwave extraction. Molecules 2016, 21, 113. [Google Scholar] [CrossRef] [PubMed]
- Katiki, L.M.; Barbieri, A.M.E.; Araujo, R.C.; Veríssimo, C.J.; Louvandini, H.; Ferreira, J.F.S. Synergistic interaction of ten essential oils against Haemonchus contortus in vitro. Vet. Parasitol. 2017, 243, 47–51. [Google Scholar] [CrossRef] [PubMed]
- Politeo, O.; Jukic, M.; Milos, M. Chemical composition and Antioxidant capacity of free volatile aglycones from Basil (Ocimum Basilicum L.) compared with its essential oil. Food Chem. 2007, 101, 379–385. [Google Scholar] [CrossRef]
- Goñi, M.L.; Gañán, N.A.; Strumia, M.C.; Martini, R.E. Eugenol-loaded LLDPE films with antioxidant activity by supercritical carbon dioxide impregnation. J. Supercrit. Fluids 2016, 111, 28–35. [Google Scholar] [CrossRef]
- U.S. Food & Drug. Available online: https://www.fda.gov/drugs/new-drugs-fda-cders-new-molecular-entities-and-new-therapeutic-biological-products/novel-drug-approvals-2022 (accessed on 29 September 2022).
- Carson, C.F.; Hammer, K.A. Chemistry and bioactivity of essential oils. In Lipids and Essential Oils as Antimicrobial Agents; John Wiley & Sons: Chichester, UK, 2011; pp. 203–238. [Google Scholar]
- Bakkali, F.; Averbeck, S.; Averbeck, D.; Idaomar, M. Biological effects of essential oils—A review. Food Chem. Toxicol. 2008, 46, 446–475. [Google Scholar] [CrossRef]
- O’Bryan, C.A.; Pendleton, S.J.; Crandall, P.G.; Ricke, S.C. Potential of plant essential oils and their components in animal agriculture - in vitro studies on antibacterial mode of action. Front. Vet. Sci. 2015, 2, 35. [Google Scholar] [CrossRef]
- Saad, N.Y.; Muller, C.D.; Lobstein, A. Major bioactivities and mech anism of action of essential oils and their components. Flavour Fragr. J. 2013, 28, 269–352. [Google Scholar] [CrossRef]
- Burt, S. Essential oils: Their antibacterial properties and potential applications in foods—A review. Int. J. Food Microbiol. 2004, 94, 223–253. [Google Scholar] [CrossRef]
- Bruni, R.; Medici, A.; Andreotti, E.; Fantin, C.; Muzzoli, M.; Dehesa, M.; Romagnoli, C.; Sacchetti, G. Chemical composition and biological activities of Ishpingo essential oil, a traditional Ecuadorian spice from Ocotea quixos (Lam.) Kosterm (Lauraceae) flower calices. Food Chem. 2004, 85, 415–421. [Google Scholar] [CrossRef]
- Shankar, J.R.; Mohan, S.K. A status review on the medicinal properties of essential oils. Ind. Crops Prod. 2014, 62, 250–264. [Google Scholar]
- Dakole, C.H.; Nguefack, J.; Lekagne, J.B.D. Antifungal potential of essential oils, aqueous and ethanol extracts of thirteen plants against Fusarium oxysporum sp. lycopersici and Phytophtora infestans (Mont.) de Bary as major tomato pathogens in Cameroon. Int. J. Curr. Sci. 2016, 19, 128–145. [Google Scholar]
- Kocic-Tanackov, S.; Dimic, G.; Levic, J.; Tanackov, I.; Tuco, D. Antifungal activities of basil (Ocimum basilicum L.) extract on Fusarium species. Afr. J. Biotechnol. 2011, 10, 10188–10195. [Google Scholar]
- Nosrati, S.; Hosseini, S.A.E.; Sarpeleh, A.; Shahrbabak, M.S.; Shahrbabk, Y.S. Antifugal activity of Spearmint (Metha Spicata L.) essential oil on Fusarium oxysporum f. sp. radicis-cucumerinum the causal agent of stem and crown of greenhouse cucumber in Yazd, Iran. In Proceedings of the International Conference on Environmental and Agriculture Engineering IPCBEE, Chengdu, China, 29–31 July 2011; Volume 15, pp. 52–56. [Google Scholar]
- Pawar, V.C.; Thaker, V.S. Evaluation of the anti-Fusarium oxysporum f. sp cicer and Alternaria porri effects of some essential oils. World J. Microbiol. Biotechnol. 2007, 23, 1099–1106. [Google Scholar] [CrossRef]
- Oxenham, S.K.; Svoboda, K.P.; Walters, D.R. Antifungal activity of the essential oil of Basil (Ocimum basilicum). J. Phytopathol. 2005, 153, 174–180. [Google Scholar] [CrossRef]
- Gurav, T.P.; Dholakia, B.B.; Ashok, P.; Giri, A.P. A glance at the chemodiversity of Ocimum species: Trends, implications, and strategies for the quality and yield improvement of essential oil. Phytochem. Rev. 2021, 21, 879–913. [Google Scholar] [CrossRef]
- Lucini, E.I.; Zunino, M.P.; López, M.L.; Zygadlo, J.A. Effect of Monoterpenes on Lipid Composition and Sclerotial Development of Sclerotium cepivorum Berk. J. Phytopathol. 2006, 154, 441–446. [Google Scholar] [CrossRef]
- Sharma, S.; Tripathi, A. Effects of Citrus sinensis (L.) Osbeck epicarp essential oil on growth and morphogenesis of Aspergillus niger (L.) Van Tieghem. Microb. Res. 2008, 163, 337–344. [Google Scholar] [CrossRef]
- Carovic-Stanko, K.; Orlic, S.; Politeom, O.; Strikic, F.; Kolak, I.; Milos, M.; Satovic, Z. Composition and antibacterial activities of essential oils of seven Ocimum taxa. Food Chem. 2010, 119, 196–201. [Google Scholar] [CrossRef]
- Badaway, M.E.I.; Abdelgaleil, S.A.M. Composition and antimicrobial activity of essential oils isolated from Egyptian plants against plant pathogenic bacteria and fungi. Ind. Crops Prod. 2014, 52, 776–782. [Google Scholar] [CrossRef]
- Salvi, P.; Kumar, G.; Gandass, N.; Kajal; Verma, A.; Rajarammohan, S.; Rai, N.; Gautam, V. Antimicrobial potential of essential oils from aromatic plant Ocimum sp.; A comparative biochemical profiling and in-silico analysis. Agronomy 2022, 12, 627. [Google Scholar] [CrossRef]

| The Method of Use | Treatment Method | The Conditions Addressed |
|---|---|---|
| Powders—grinding of dried inflorescences followed by sieving. | 1.5 g of basil plant remains under the tongue for 2 min, then swallowed with water (3–4 times/day on an empty stomach). | Nutritional disorders Atherosclerosis Myocardial infarction Bronchial asthma Infection with carcinogenic papilloma viruses Mental stress Neurovegetative disorders Chronic fatigue syndrome Nightmares, sleep disorders Adjuvant in depression, Anxious depression, Neurosis Headaches Respiratory viruses, Flu Acute bronchitis Corneal rhinitis Sinusitis Rheumatoid arthritis Infectious eczema Menstrual cramps etc. |
| Hot infusion—10 g of stems with crushed flowers are scalded in a cup of boiling water, and after 15 min of infusion are filtered. | It is usually consumed hot for maximum effect (antispasmodic, hyperthermic, and relaxing purposes). | |
| Combined infusion—combines cold extraction with hot infusion. 2–3 teaspoons of chopped basil flowers and leaves are left to soak in ½ cup of water (from evening to morning), then filtered. Another portion of chopped plants is scalded with another ½ cup of hot water for 20 min, after which it is left to cool and then filtered. The two extracts are combined. | It is consumed before each meal (15 min before). | |
| Tincture—after filling ½ of the jar with basil powder, the rest of volume is filled with 50 °C alcohol. It is left to macerate for 8 days, after which it is filtered and stored in dark bottles to avoid the light. | It is used 2–3 times a week. | |
| Volatile essential oil—obtained by industrial processes, steam entrainment, etc. | It is used for internal applications, administered 3 drops dissolved in honey or in water, 2–4 times/day (cure of 5–14 days). For children between 8 and 12 years old, the dose is halved, and for those between 5 and 8 years old, 1 drop/2 times a day is usually administered. | |
| Therapeutic baths—the basil is left to soak in 3–5 L of warm water for 12 h, after which it is filtered. The obtained maceration is set aside, and the remaining plant is scalded with 1 L of water, then left to infuse for 15 min. | Basil baths last 20–30 min, with physical and mental tonic effects, helping the body fight against infections and diseases associated with cold. |
| Compound | Molecular Formula | Molecular Weight (g/mol) | RT | EO1 *(Area %) | EO2 *(Area %) |
| Pinene | C10H16 | 136.24 | 9.68 | nd | 0.92 |
| Myrcene | C10H16 | 136.23 | 13.62 | nd | 0.95 |
| Cineol | C10H18O | 154.24 | 15.09 | 2.63 | 7.29 |
| Camphor | C10H16O | 152.23 | 25.28 | 0.60 | nd |
| Linalool | C10H18O | 154.25 | 26.32 | 32.66 | 52.18 |
| Linalyl acetate | C12H20O2 | 196.29 | 26,35 | 0.45 | 2.74 |
| Bornyl acetate | C12H20O2 | 196.28 | 27.04 | 0.38 | nd |
| Bergamontene | C15H24 | 204.33 | 27.17 | nd | 1.13 |
| α-Guaiene | C15H24 | 204.35 | 27.28 | 2.64 | 3.54 |
| Caryophyllene | C15H24 | 204.36 | 27.39 | 1.19 | 2.87 |
| Estragole | C10H12O | 148.20 | 29.30 | 42.71 | 3.93 |
| Terpineol α | C10H18O | 154.25 | 29.66 | 0.40 | 0.84 |
| Germacrene D | C15H24 | 204.35 | 30.05 | 4.47 | 4.76 |
| Guaiadiene | C15H24 | 204.35 | 30.25 | 2.18 | 2.87 |
| Elemene α | C15H24 | 204.36 | 30.55 | 1.15 | 2.40 |
| Elemene β | C15H24 | 204.35 | 31.19 | 2.00 | 5.10 |
| Cubenol | C15H26O | 222.37 | 31.23 | 2.31 | nd |
| Eugenol | C10H12O2 | 164.20 | 39.34 | 0.81 | 5.31 |
| Cadinol | C15H26O | 222.37 | 39.65 | 3.07 | 3.16 |
| Total of major compounds | 16 compounds identified (13 compounds common for both varieties representing over 99.65% and 99.99%) | ||||
| Classes | EO1 | EO2 | |||
| Monoterpenes hydrocarbons | 3.46 | 11.90 | |||
| Monoterpenes oxigenated | 76.37 | 56.95 | |||
| Sesquiterpene | 19.01 | 25.83 | |||
| Others | 0.81 | 5.31 | |||
| Compound Name | Molecular Formula | Molecular Weight (g/mol) | RT | FW1 *(Area %) | FW2 *(Area %) |
| Cineol | C10H18O | 154.24 | 14.27 | 5.98 | 10.19 |
| Fenchone | C10H16O | 152.23 | 21.23 | 0.13 | 0.59 |
| Linalool oxide | C10H18O2 | 170.25 | 23.84 | 0.08 | 0.06 |
| Camphor | C10H16O | 152.23 | 24.58 | 1.91 | 1.24 |
| Linalool | C10H18O | 154.25 | 25.65 | 68.08 | 59.58 |
| α-Guaiene | C15H24 | 204.35 | 27.23 | 0.21 | 0.45 |
| Phenylacetaldehyde | C8H8O | 120.15 | 28.28 | 0.08 | nd |
| Estragole | C10H12O | 148.20 | 28.59 | 9.54 | 0.58 |
| Terpineol α | C10H18O | 154.25 | 29.45 | 1.53 | 1.51 |
| Nerol | C10H18O | 154.25 | 32.80 | 0.72 | 0.57 |
| Eugenol | C10H12O2 | 164.20 | 39.21 | 7.73 | 24.77 |
| Chavicol | C9H10O | 134.18 | 41.94 | 0.75 | 0.08 |
| Dioctyl phthalate | C24H38O4 | 390.55 | 43.66 | 2.02 | nd |
| Cumarina | C9H6O2 | 146.14 | 44.25 | 0.16 | 0.08 |
| Total of major compounds | 14 compounds identified (12 compounds common for both varieties representing over 98.92% and 99.70%) | ||||
| Classes | FW1 | FW2 | |||
| Monoterpenes hydrocarbons | 6.19 | 10.84 | |||
| Oxygenated monoterpenes | 81.78 | 63.42 | |||
| Sesquiterpene | 0.93 | 1.22 | |||
| Others | 10.02 | 24.22 | |||
| Compound Name | EO1 * (g, %) | EO2 * (g, %) | FW1 * (g, %) | FW2 * (g, %) |
|---|---|---|---|---|
| Linalool | 39.29 | 55.51 | 13.70 | 0.09 |
| Estragole | 31.48 | 9.78 | 1.04 | 0.30 |
| Eugenol | 5.42 | 7.63 | 0.43 | 0.32 |
| Methods | EO1 * | EO2 * | FW1 * | FW2 * |
|---|---|---|---|---|
| DPPH a (IC50 g L−1) | 15.47 ± 0.5 | 0.85 ± 0.01 | 893.63 ± 1.51 | 124.50 ± 0.33 |
| ABTS a (mM Trolox g−1) | 0.08 ± 0.00 | 0.20 ± 0.00 | 0.45 ± 0.01 | 1.08 ± 0.02 |
| FRAP (mM Trolox g−1) | 22.46 ± 0.72 | 28.45 ± 0.46 | 0.11 ± 0.00 | 0.24 ± 0.00 |
| Compound | Conc * % | Mycelial Growth Rate (cm) | E ** % | |||
|---|---|---|---|---|---|---|
| 3 Days | 5 Days | 7 Days | 10 Days | |||
| Control sample | - | 1.40 | 2.60 | 3.45 | 3.80 | - |
| Linalool | 100 | 0 | 0 | 0 | 0 | 100 |
| 50 | 0 | 0 | 0 | 0 | 100 | |
| 25 | 0 | 0.45 | 1.57 | 3.34 | 12.17 | |
| Estragole | 100 | 0 | 0.40 | 1.41 | 2.81 | 25.99 |
| 50 | 0 | 1.11 | 2.05 | 3.53 | 13.82 | |
| 25 | 0.56 | 1.72 | 2.67 | 3.75 | 1.32 | |
| Eugenol | 100 | 0 | 0 | 0 | 0 | 100 |
| 50 | 0 | 0 | 0 | 0 | 100 | |
| 25 | 0 | 0 | 0 | 0 | 100 | |
Publisher’s Note: MDPI stays neutral with regard to jurisdictional claims in published maps and institutional affiliations. |
© 2022 by the authors. Licensee MDPI, Basel, Switzerland. This article is an open access article distributed under the terms and conditions of the Creative Commons Attribution (CC BY) license (https://creativecommons.org/licenses/by/4.0/).
Share and Cite
Stan, C.; Nenciu, F.; Muscalu, A.; Vlăduț, V.N.; Burnichi, F.; Popescu, C.; Gatea, F.; Boiu-Sicuia, O.A.; Israel-Roming, F. Chemical Composition, Antioxidant and Antimicrobial Effects of Essential Oils Extracted from Two New Ocimum basilicum L. Varieties. Diversity 2022, 14, 1048. https://doi.org/10.3390/d14121048
Stan C, Nenciu F, Muscalu A, Vlăduț VN, Burnichi F, Popescu C, Gatea F, Boiu-Sicuia OA, Israel-Roming F. Chemical Composition, Antioxidant and Antimicrobial Effects of Essential Oils Extracted from Two New Ocimum basilicum L. Varieties. Diversity. 2022; 14(12):1048. https://doi.org/10.3390/d14121048
Chicago/Turabian StyleStan (Tudora), Cătalina, Florin Nenciu, Adriana Muscalu, Valentin Nicolae Vlăduț, Floarea Burnichi, Carmen Popescu, Florentina Gatea, Oana Alina Boiu-Sicuia, and Florentina Israel-Roming. 2022. "Chemical Composition, Antioxidant and Antimicrobial Effects of Essential Oils Extracted from Two New Ocimum basilicum L. Varieties" Diversity 14, no. 12: 1048. https://doi.org/10.3390/d14121048
APA StyleStan, C., Nenciu, F., Muscalu, A., Vlăduț, V. N., Burnichi, F., Popescu, C., Gatea, F., Boiu-Sicuia, O. A., & Israel-Roming, F. (2022). Chemical Composition, Antioxidant and Antimicrobial Effects of Essential Oils Extracted from Two New Ocimum basilicum L. Varieties. Diversity, 14(12), 1048. https://doi.org/10.3390/d14121048

